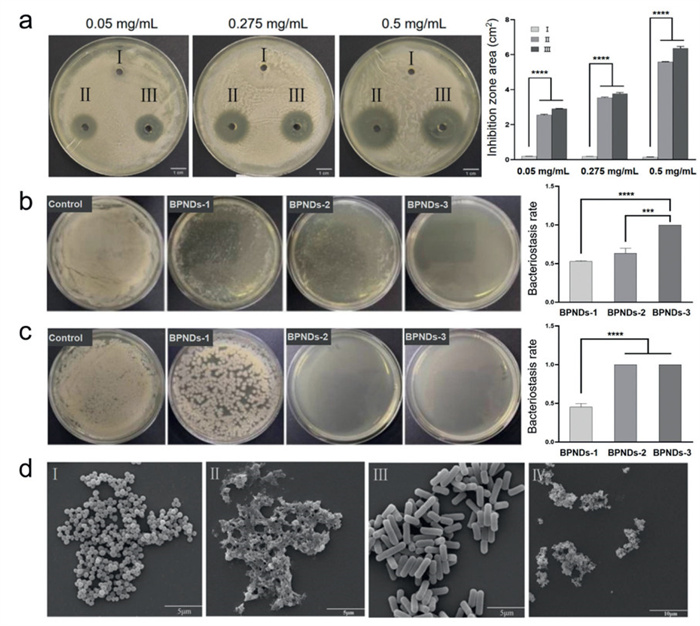

-
[1]
Zhiqi Hu
, Lingling Wu
, Duo Zhang
, Yixue An
, Jiao Wang
, Binbin Zhao
, Robert Chunhua Zhao
, Rong Cao
, Xue Yang
. Ultrathin transparent metal-organic framework-based nanocomposite membranes for antibacterial wound healing. Chinese Journal of Structural Chemistry,
2025, 44(12): 100749-100749.
doi: 10.1016/j.cjsc.2025.100749
-
[2]
Yuanpeng Ye
, Longfei Yao
, Guofeng Liu
. Engineering circularly polarized luminescence through symmetry manipulation in achiral tetraphenylpyrazine structures. Chinese Journal of Structural Chemistry,
2025, 44(2): 100460-100460.
doi: 10.1016/j.cjsc.2024.100460
-
[3]
Sifan Du
, Yuan Wang
, Fulin Wang
, Tianyu Wang
, Li Zhang
, Minghua Liu
. Evolution of hollow nanosphere to microtube in the self-assembly of chiral dansyl derivatives and inversed circularly polarized luminescence. Chinese Chemical Letters,
2024, 35(7): 109256-.
doi: 10.1016/j.cclet.2023.109256
-
[4]
Hao Zhang
, Hao Liu
, Ke Huang
, Qingxiu Xia
, Hongjie Xiong
, Xiaohui Liu
, Hui Jiang
, Xuemei Wang
. Ionic exchange based intracellular self-assembly of pitaya-structured nanoparticles for tumor imaging. Chinese Chemical Letters,
2025, 36(6): 110281-.
doi: 10.1016/j.cclet.2024.110281
-
[5]
Yuyao Guan
, Baoting Yu
, Jun Ding
, Tingting Sun
, Zhigang Xie
. BODIPY photosensitizers for antibacterial photodynamic therapy. Chinese Chemical Letters,
2025, 36(8): 110645-.
doi: 10.1016/j.cclet.2024.110645
-
[6]
Ting Zhang
, Deqiang Chen
, Ningzhi Zhang
, Mingxu Zhang
, Qiang Huang
, Wei Liu
, Ran Gao
, Yong Zhang
. Self-assembled supramolecular nanofibers integrate pH-responsive drug delivery and antimicrobial for combined cancer therapy. Chinese Chemical Letters,
2026, 37(2): 111117-.
doi: 10.1016/j.cclet.2025.111117
-
[7]
Shaobo Wang
, Honggui Yang
, Chunni Zhao
, Deyu Hu
, Baoan Song
. Antibacterial agrochemicals: Recent research progress and outlook. Chinese Chemical Letters,
2026, 37(1): 111543-.
doi: 10.1016/j.cclet.2025.111543
-
[8]
Yue Ren
, Kang Li
, Yi-Zi Wang
, Shao-Peng Zhao
, Shu-Min Pan
, Haojie Fu
, Mengfan Jing
, Yaming Wang
, Fengyuan Yang
, Chuntai Liu
. Swelling and erosion assisted sustained release of tea polyphenol from antibacterial ultrahigh molecular weight polyethylene for joint replacement. Chinese Chemical Letters,
2025, 36(2): 110468-.
doi: 10.1016/j.cclet.2024.110468
-
[9]
Xicheng Li
, Dong Mo
, Shoushan Hu
, Meng Pan
, Meng Wang
, Tingyu Yang
, Changxing Qu
, Yujia Wei
, Jianan Li
, Hanzhi Deng
, Zhongwu Bei
, Tianying Luo
, Qingya Liu
, Yun Yang
, Jun Liu
, Jun Wang
, Zhiyong Qian
. A Pt@ZIF-8/ALN-ac/GelMA composite hydrogel with antibacterial, antioxidant, and osteogenesis for periodontitis. Chinese Chemical Letters,
2025, 36(9): 110674-.
doi: 10.1016/j.cclet.2024.110674
-
[10]
Xiangrong Pan
, Xixi Hou
, Yuhang Du
, Zhixin Pang
, Shiyang He
, Lan Wang
, Jianxue Yang
, Longfei Mao
, Jianhua Qin
, Haixia Wu
, Baozhong Liu
, Zhan Zhou
, Lufang Ma
, Chaoliang Tan
. Solvent-mediated synthesis of 2D In-TCPP MOF nanosheets for enhanced photodynamic antibacterial therapy. Chinese Chemical Letters,
2025, 36(12): 110536-.
doi: 10.1016/j.cclet.2024.110536
-
[11]
Mengyao Gao
, Shan Sun
, Hengwei Lin
, Cheng Yang
. A multifunctional carbon dot-based nanoplatform for antibacterial therapy: Integrating photodynamic, photothermal, and gas treatments. Chinese Chemical Letters,
2026, 37(2): 111055-.
doi: 10.1016/j.cclet.2025.111055
-
[12]
Yuwen Zhu
, Xiang Deng
, Yan Wu
, Baode Shen
, Lingyu Hang
, Yuye Xue
, Hailong Yuan
. Formation mechanism of herpetrione self-assembled nanoparticles based on pH-driven method. Chinese Chemical Letters,
2025, 36(1): 109733-.
doi: 10.1016/j.cclet.2024.109733
-
[13]
Ze Cao
, Chenqi Ge
, Yating Wu
, Hua Tang
, Yueyan Kuang
, Yuyang Wu
, Hao Li
. Self-assembled chiral cages for anion recognition. Chinese Chemical Letters,
2026, 37(3): 111554-.
doi: 10.1016/j.cclet.2025.111554
-
[14]
Shengyong Liu
, Hui Li
, Wei Zhang
, Yan Zhang
, Yan Dong
, Wei Tian
. Multiple host-guest and metal coordination interactions induce supramolecular assembly and structural transition. Chinese Chemical Letters,
2025, 36(6): 110465-.
doi: 10.1016/j.cclet.2024.110465
-
[15]
Chengde Wang
, Liping Huang
, Shanshan Wang
, Lihao Wu
, Yi Wang
, Jun Dong
. A distinction of gliomas at cellular and tissue level by surface-enhanced Raman scattering spectroscopy. Chinese Chemical Letters,
2024, 35(5): 109383-.
doi: 10.1016/j.cclet.2023.109383
-
[16]
Shuang Liang
, Jianjun Yao
, Dan Liu
, Mengli Zhou
, Yong Cui
, Zhaohui Wang
. Tumor-responsive covalent organic polymeric nanoparticles enhancing STING activation for cancer immunotherapy. Chinese Chemical Letters,
2025, 36(3): 109856-.
doi: 10.1016/j.cclet.2024.109856
-
[17]
Chengying Wang
, Bohan Chen
, Yuming Wang
, Bingyu Xie
, Peishuang Yu
, Xiaojie Xu
, Rui Wang
, Lin Miao
, Xiaohui Yan
, Yubo Li
, Yunfei Li
, Wei Huang
. Advances of nanomedicine targeting the interface of cholesterol metabolism and immune evasion. Chinese Chemical Letters,
2025, 36(12): 110921-.
doi: 10.1016/j.cclet.2025.110921
-
[18]
Feng Cui
, Fangman Chen
, Xiaochun Xie
, Chenyang Guo
, Kai Xiao
, Ziping Wu
, Yinglu Chen
, Junna Lu
, Feixia Ruan
, Chuanxu Cheng
, Chao Yang
, Dan Shao
. Scalable production of mesoporous titanium nanoparticles through sequential flash nanocomplexation. Chinese Chemical Letters,
2024, 35(4): 108681-.
doi: 10.1016/j.cclet.2023.108681
-
[19]
Xiaoliu Liang
, Chunliu Huang
, Hui Liu
, Hu Chen
, Jiabao Shou
, Hongwei Cheng
, Gang Liu
. Natural hydrogel dressings in wound care: Design, advances, and perspectives. Chinese Chemical Letters,
2024, 35(10): 109442-.
doi: 10.1016/j.cclet.2023.109442
-
[20]
Haijun Shen
, Yi Qiao
, Chun Zhang
, Yane Ma
, Jialing Chen
, Yingying Cao
, Wenna Zheng
. A matrix metalloproteinase-sensitive hydrogel combined with photothermal therapy for transdermal delivery of deferoxamine to accelerate diabetic pressure ulcer healing. Chinese Chemical Letters,
2024, 35(12): 110283-.
doi: 10.1016/j.cclet.2024.110283

 Login In
Login In







 DownLoad:
DownLoad: